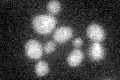
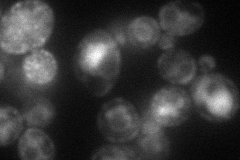

View description
DnaJ-like chaperone required for nuclear membrane fusion during mating, localizes to the ER membrane; exhibits genetic interactions with KAR2
Localization:
Intensity:
Fold change:
Significance:
-
C’ GFP library in SD
below threshold18.27 -
N' NOP1pr-GFP in SD

ER,punctate74.182 -
N' TEF2pr-mCherry in SD
ER,vacuole55.8525 -
N' NATIVEpr-GFP in SD

below threshold18.4298 -
N' TEF2pr-VC and Cyto-VN in SD

#N/A0 -
C’ GFP library in SD+DTT

cytosolN/AN/ANo -
C’ GFP library in SD+H2O2

cytosol15.860.86No -
C’ GFP library in Starvation Media

cytosol17.210.94No -
C’ GFP library on the background of Pup2-DaMP

below threshold -
C’ GFP library on the background of CCT mutant

below threshold15.66810.857133No
